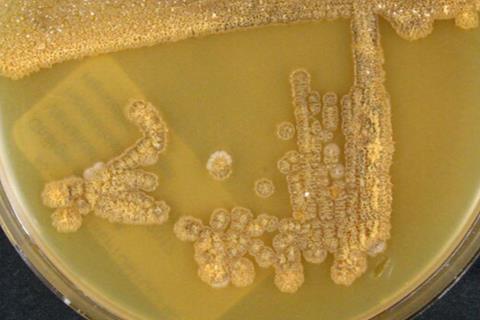
Amycolatopsis_orientalis_subsp._orientalis_(Pittenger_and_Brigham_1956)_Lechevalier_et_al._1986

By uncovering an unexpected enzyme activity and combining it with precise metabolic engineering, a team of scientists has transformed Escherichia coli into a microbial factory capable of producing gram-per-liter levels of optically pure S-HIV from renewable carbon sources.
α-Hydroxy acids are essential ingredients in a wide range of products, from cosmetics and biomedical materials to biodegradable plastics. Among them, 2-hydroxyisovalerate (2-HIV) has attracted growing interest because it can serve both as a diagnostic metabolite and as a monomer for advanced biopolymers with tunable mechanical strength and degradation behavior.
However, 2-HIV exists in two mirror-image forms, R and S, and many applications require a single, well-defined enantiomer. Until now, nearly all microbial biosynthesis efforts focused on producing the R-form of 2-HIV. No efficient biological route was available for the S-enantiomer, limiting access to optically pure S-HIV and constraining its broader use in synthetic biology and sustainable materials. Developing a stereoselective, bio-based production strategy for S-HIV therefore represents a critical missing piece in green chemical manufacturing.
Microbial platform
A study (DOI: 10.1016/j.bidere.2025.100059) published in BioDesign Research on 8 October 2025 by Shizhen Wang’s & Jifeng Yuan’s team, Xiamen University, establishes the first efficient microbial platform for stereoselective S-2-hydroxyisovalerate biosynthesis, revealing new catalytic potential of Fe(II)-dependent dioxygenases and enabling sustainable production of chiral α-hydroxy acids from renewable feedstocks.
READ MORE: Study reviews valorization of depolymerized lignin using microorganisms
READ MORE: Engineered yeast strain can selectively overproduce carotenoids
Using a stepwise biocatalysis-to-strain-engineering workflow, the researchers first tested whether the Fe(II)-dependent dioxygenase HmaS (from Amycolatopsis orientalis), known for hydroxylation–decarboxylation of aromatic ketoacids, could accept an aliphatic substrate relevant to leucine metabolism.
They built a whole-cell enzyme cascade in E. coli by co-expressing L-amino acid deaminase (PmLAAD) and HmaS, so that PmLAAD converts L-leucine → 2-keto-4-methyl-pentanoate (2-KMP) and HmaS then converts 2-KMP → 2-HIV; protein expression was confirmed by SDS–PAGE (HmaS ~35–40 kDa), and product identity was verified by LC–MS/MS (diagnostic fragments at m/z 117.0538 and 71.0484) plus chiral analysis, which showed the product was specifically S-2-HIV—revealing a previously unreported HmaS activity on 2-KMP.
Rational enzyme engineering
Next, to reduce aromatic byproducts, they applied rational enzyme engineering at a key binding-site residue (Ser201) and created HmaS(S201F), which expressed comparably to wild type but abolished S-mandelate formation from aromatic amino acid substrates while retaining S-HIV synthesis; molecular docking supported preserved 2-KMP binding (binding energy ~−4.04 kcal/mol) and structural analyses suggested a contracted substrate channel consistent with altered specificity.
They then moved from biocatalysis to de novo pathway construction by introducing either wild-type HmaS or HmaS(S201F) into E. coli MG1655 (DE3) to couple glycolysis → leucine-pathway intermediates → 2-KMP → S-HIV: wild-type HmaS produced 1.27 mM S-HIV but accumulated substantial S-HMA/S-MA, whereas HmaS(S201F) produced ~1.0 mM S-HIV with only trace byproducts and confirmed product identity by matching retention time and MS fragmentation.
Finally, they performed modular leucine-pathway optimization (introducing AlsS, overexpressing ilvCD, and balancing leuABCD expression) to avoid bottlenecks from excess 2-KMP, reaching 8.1 mM S-HIV in shake flasks (40 g/L glycerol, 72 h) and 33.9 mM (4.0 g/L) in 2-L fed-batch fermentation (OD600 ~16.2, 159 h), while noting acetate overflow (>300 mM) as a key scale-up challenge that could be addressed by targeted byproduct-pathway deletions in future work.
Sustainable alternative
This work establishes the first efficient microbial route to optically pure S-HIV, offering a sustainable alternative to traditional chemical synthesis. The platform opens new opportunities for producing chiral monomers used in biodegradable polymers, specialty chemicals, and potentially pharmaceutical intermediates.
More broadly, the discovery that HmaS can act on aliphatic α-keto acids highlights an underexplored catalytic potential within iron-dependent dioxygenases, suggesting that many more valuable chiral molecules could be accessed through enzyme repurposing.
Topics
- 2-hydroxyisovalerate
- Amycolatopsis orientalis
- Asia & Oceania
- Bacteria
- Bioengineering
- biopolymers
- chiral α-hydroxy acids
- Economic Equality
- Escherichia coli
- Fe(II)-dependent dioxygenases
- Healthy Land
- Innovation News
- Jifeng Yuan
- mirror-image forms
- Proteomics & Enzymology
- Shizhen Wang
- Sustainable Microbiology
- Synthetic Biology
- Xiamen University
No comments yet